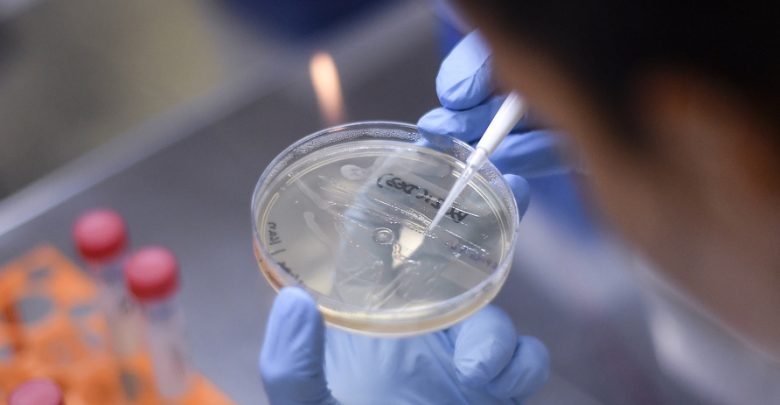

لقاح محتمل لكورونا يحقق نتائج مبشرة
قال علماء أمريكيون، أمس الخميس، إن تجارب أولية على الفئران لإنتاج لقاح محتمل لمرض كوفيد-19 أظهرت أنها قد تحفز على رد فعل مناعي ضد فيروس كورونا المستجد عند مستويات قد تمنع الإصابة.
وأكد فريق في كلية طب بيتسبرغ في الولايات المتحدة إنه استطاع التحرك سريعا نحو تطوير لقاح محتمل لكوفيد-19 بعد العمل على فيروسات كورونا أخرى تسبب مرض الالتهاب الرئوي الحاد ومتلازمة الشرق الأوسط التنفسية.
ولدى تجربته على الفئران، استطاع النموذج الأولي للقاح الذي أطلق عليه الباحثون بيتكو فاك أن يحدث ما وصفوه “باندفاع متصاعد للأجسام المضادة” لفيروس كورونا المستجد خلال أسبوعين.
ولفت الباحثون إلى أن من المبكر للغاية تحديد ما إذا كانت الاستجابة المناعية ضد كوفيد-19 ستكون فعالة ولأي فترة.
وقال الفريق إنه يأمل أن يبدأ في تجربة اللقاح المقترح على البشر في تجارب سريرية خلال الأشهر القليلة القادمة.
ويعمل الباحثون عبر أنحاء العالم على تطوير علاجات محتملة أو لقاحات للمرض الذي يصيب الجهاز التنفسي وأودى بحياة نحو 47 ألف شخص وأصاب مليون شخص تقريبا خلال أشهر قليلة.



